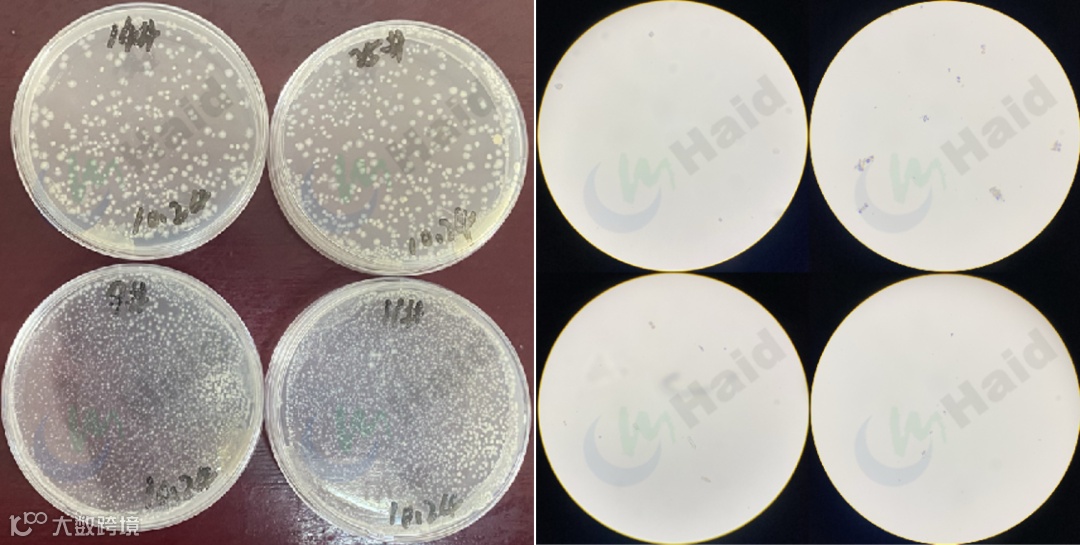

文 | 图
浙江海大 曹毅 夏腾
“曹工,我家今晚7点出虾,你一定要过来,3500斤的棚等着你呢”,林老板兴奋地给我打电话说到。
“必须到,林老板!”我听到消息同样开心,因为今年秋虾选取了2张棚持续跟进水质、投喂数据,通过方案验证,养殖120天氨氮依旧稳定在0.2-0.3,亚盐稳定在0.5以下,解决了亚盐升高导致减料、甚至掉肉段问题。
晚上大老远就听到水车发动机的声音,林老板看到我,激动地抱着我说:“我应该是这附近产量最高的了,终于不再担心亚盐问题了”。

听了深圳虾贩子的讲述才知道棚产3300斤,回捕率97%,看着活力满满的虾不禁感慨万千;也借此机会把总结的一些技术方案和大家分享一下,希望在虾价低迷、问题重重的环境下帮大家解决一些实际的养殖问题。
林老板8月18日放苗,养殖前50天一直使用“传统补肥”方式进行调水(氨基酸肥为主);邻居张老板处为8月4日放苗,操作手法则是“高菌高碳”。


因此,各选取2张棚(共4张棚)进行连续跟进,跟进指标包括水质、投喂、TOC、TN以及总菌等,旨在探究不同养殖模式下水质及投喂的区别。
相同的养殖区域,相同的高档料(虾多康),养殖52天时,饲料累计投喂相差254斤/棚(6-7包料)。

结合氨氮、亚盐整体分析,发现氨氮下降时亚盐上升,反之也证明两个客户水体氮循环通路是顺畅的。
单单分析氨氮或亚盐发现,林老板的氨氮、亚盐含量整体比张老板的要高,风险更大。

分析亚盐与C/N的关系发现:C/N比和亚盐具有显著的负相关关系,C/N比值越大,亚盐含量越低。
分析张老板与林老板数据发现:张老板(高菌高碳模式)C/N比维持在15以上,林老板(传统补肥模式)则在15以下。

我们发现张老板的水体总菌数明显高于林老板,这也证明了C/N比稳定≥15的情况下,利于菌的繁殖,也印证了能有效降低氨氮、亚盐的是菌,而不是藻(藻相也在持续观察,且发现该阶段藻类较少)。
海联科3102(光合菌)3斤/次,采用“以菌为主”,虾多宝泡菌(em菌)5-7斤/次,补菌均为3-4天/次。
两个客户在此阶段均采用“菌肥同补”:海联科泡肥方案。
张老板:海联科活水灵(芽孢)3两+菌藻旺4斤+虾多宝泡菌7-10斤+海联科3102 5斤;
林老板:海联科泡肥方案。

①养殖前期,两个客户处理均没问题,以菌为主保证水质清爽,尽可能将氨氮、亚盐出现的时间延后,有利于稳定加料。但相比而言,张老板通过定期补充碳源,为菌提供碳源及营养,更确保氨氮、亚盐能被及时吸收、转化。
②养殖前中期,两个客户处理也均没问题,该阶段正处于水体转浑期,水体透明度下降,菌藻无法维持平衡,通过“菌肥同补”,确保水体稳定,不掉清。但相比而言,张老板提前进行补菌+补肥,降低水掉清的风险,值得借鉴。
③养殖第中后期,通过数据分析来看,通过采取“高菌高碳”模式更能控制水体氨氮、亚盐的含量,这也正是张老板处能持续加料的原因;而不补充氨基酸肥的原因在于养殖过程中随着虾子的生长,排泄物、饲料投喂量以及水体有机质增多,这些都是优质的氮源,因此不再需要额外补充。
而且,在天气不稳定时,强行添加氨基酸肥,只会提高水体氨氮的含量,增加养殖风险。
因亚盐持续升高,担心无法正常加料,交流“高菌高碳”养殖模式后,林老板准备尝试尝试。
①转变方法后饲料投喂量稳步上升,最高日投喂60斤/棚,养殖103天投喂量达2700斤。
②亚盐随着饲料投喂的升高反而下降,最后基本维持在0.3-0.5之间。

转变方法后氨氮持续稳定在0.2-0.3之间,亚盐也在同步下降,并未出现“氨氮降低,亚盐升高”或“亚盐降低,氨氮升高”情况。

通过“高菌高碳”模式,水体C/N比均>15,且整体趋势变为随着C/N比值上升,亚盐含量下降。

转变养殖操作,以“高菌高碳模式”为主:
①上午虾多宝泡菌10-15斤+菌藻旺5斤,中午3102 5斤/棚;
②次日活水灵3两/棚;
③第三天,往返交替,两周/次海联科补肥套餐。

所谓的“高菌高碳”模式,就是目前市面上比较火的“碳模式”。
通过碳源激活菌类,再以“NH4+1.18C6H12O6+HCO3+2.06O2 → C5H7O2N+6.06H2O+3.07CO2”的形式达到以碳促氮的目的,最终快速分解、吸收水体有机质以及氨氮、亚盐。而在这个过程中,只有C/N比≥15时,菌类才能更快地吸收氨氮、亚盐;同时,随着菌类数量的增加,更有利于形成生物絮团,达到更加稳定地控制水体环境的目的。
提高C/N比值除了补充碳源,也可以减少氮源的摄入;而添加乳酸菌等促进肠道消化以及合理投喂,使用优质饲料(浙江海大虾多康),提高饲料利用率等,也是养殖中常用的方式。
养殖前期:

养殖中前期(转浑期):

养殖中后期:

林老板以及张老板处地下水离子含量丰富,也是亚盐有效防控以及养殖顺利的重要原因;因为我们在验证方案时发现,水体磷元素缺乏也会影响菌的生长及繁殖,从而导致方案有效率降低。
以某园区为例,该地区土质属粘土,水源水质良好,重金属含量低,但磷酸盐含量偏低。

➣通过对3个客户进行跟进,发现在相同的“高菌高碳”模式下,水体亚盐含量差异较大,因此对其水质离子进行检测时发现赵老板处的磷酸盐含量较低。

➣建议客户同期使用海联科磷钾速补2斤/棚/次,3-4天/次后进行水质检测发现:随着水体磷酸盐的增加,亚盐含量明显下降;因此可以证明,定期补充磷元素对水体稳态同样至关重要。

小棚养殖本就是一个系统工程,而随着养殖规划的改变,所有的操作、产品以及思路都在发生着翻天覆地的变化,但万变不离其中的是养殖思路一定要契合养殖模式以及品种习性,这是我们需要坚守的。
浙江海大团队结合优质养户们的处理经验,梳理市场核心养殖问题,手把手、一步步带大家揭秘水体亚盐的防控思路,旨为白虾养殖保驾护航。我们一直在路上!
跟着海大走,把钱赚到手!
浙江海大,全心全意为虾服务!
本文系海大农牧(微信号:haid002311)原创,未经授权,一律禁止转载!文章投稿、转载授权,欢迎发邮件到:haidnm@haid.com.cn
✪加海哥微信(haid-services03)
即可加入养殖交流群
及时获得养殖资讯✪


👇 咨询产品可点击"阅读原文"留言

